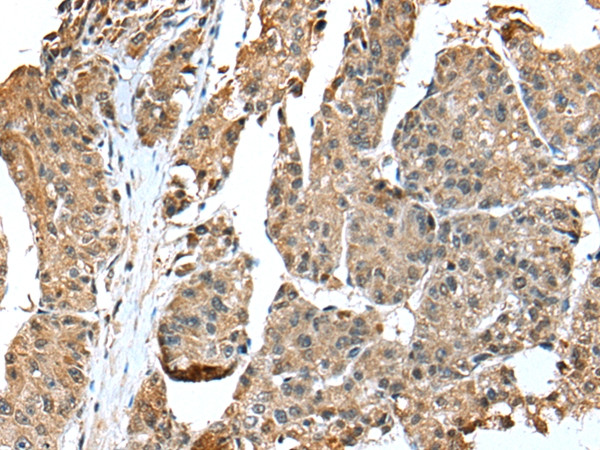
EML4 Antibody in Immunohistochemistry (Paraffin) (IHC (P))
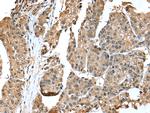
EML4 Antibody in Immunohistochemistry (Paraffin) (IHC (P))

Search
Invitrogen
EML4 Polyclonal Antibody
{{$productOrderCtrl.translations['antibody.pdp.commerceCard.promotion.promotions']}}
{{$productOrderCtrl.translations['antibody.pdp.commerceCard.promotion.viewpromo']}}
{{$productOrderCtrl.translations['antibody.pdp.commerceCard.promotion.promocode']}}: {{promo.promoCode}} {{promo.promoTitle}} {{promo.promoDescription}}. {{$productOrderCtrl.translations['antibody.pdp.commerceCard.promotion.learnmore']}}
产品信息
PA5-51181
种属反应
宿主/亚型
分类
类型
抗原
偶联物
形式
浓度
规格
纯化类型
保存液
内含物
保存条件
运输条件
RRID
产品详细信息
The antibody detects endogenous levels of total EML4 protein.
靶标信息
Transcription of protein-coding genes can be reconstituted on naked DNA with only the general transcription factors and RNA polymerase II. However, this minimal system cannot transcribe DNA packaged into chromatin, indicating that accessory factors may facilitate access to DNA. One such factor, FACT, interacts specifically with histones H2A/H2B to effect nucleosome disassembly and transcription elongation. FACT is composed of an 80 kDa subunit and a 140 kDa subunit; this gene encodes the 140 kDa subunit.
仅用于科研。不用于诊断过程。未经明确授权不得转售。
篇参考文献 (0)
生物信息学
蛋白别名: echinoderm microtubule associated protein like 4; Echinoderm microtubule-associated protein-like 4; EMAP-4; EML4/ALK fusion protein; OTTHUMP00000201447; OTTHUMP00000201455; Restrictedly overexpressed proliferation-associated protein; Ropp 120; unnamed protein product
基因别名: C2orf2; ELP120; EMAP-4; EMAPL4; EML4; ROPP120
UniProt ID: (Human) Q9HC35
Entrez Gene ID: (Human) 27436